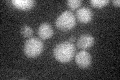
YDR420W

View description
Mucin family member that functions as an osmosensor in the Sho1p-mediated HOG pathway with Msb2p; proposed to be a negative regulator of filamentous growth; mutant displays defects in beta-1,3 glucan synthesis and bud site selection
Localization:
Intensity:
Fold change:
Significance:
-
C’ GFP library in SD
below threshold19.12 -
N' NOP1pr-GFP in SD

ER,vacuole43.4055 -
N' TEF2pr-mCherry in SD

cell periphery,vacuole18.2516 -
N' NATIVEpr-GFP in SD

cytosol,punctate32.3489 -
N' TEF2pr-VC and Cyto-VN in SD

#N/A0 -
C’ GFP library in SD+DTT

cytosol17.510.91No -
C’ GFP library in SD+H2O2

cytosol17.970.93No -
C’ GFP library in Starvation Media

cytosol18.050.94No -
C’ GFP library on the background of Pup2-DaMP

below threshold -
C’ GFP library on the background of CCT mutant

below threshold16.3050.852297No
